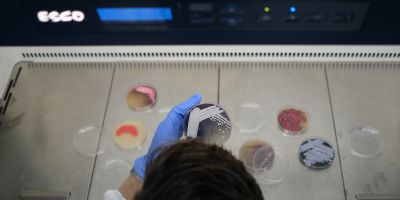

Eco-biotechnology and drug development
-
Our group works on a number of topics at the intersection of biology and chemistry.
We develop ecological and sustainable processes based on microorganisms and their enzymes. We use bioactive microbial metabolites as starting points for further structural optimization and activity enhancement. We are interested in the mechanisms of evolutionary processes that shape microbial metabolism (biosynthetic pathways, proteins, biopolymers, and bioactive secondary metabolites), as well as the dynamics of complex microbial communities.
The application of our research spans biotechnological solutions, from using microorganisms to recycle plastic waste into value-added molecules, to developing new methods for combating antibiotic-resistant pathogens. We also explore functional biomaterials for biomedical, environmental and catalytic applications, including smart biopolymer structures, antimicrobial textiles and systems for the delivery of biologically active compounds. Our work aims to integrate enzyme engineering, microbial consortium design and sustainable biotechnology to address challenges in the circular bioeconomy and green chemistry.
- Plastic and other environmental challenges through biocatalysis and synthetic biology
- “All things BIO” – biomaterials, biofilms, biosensors, biopigments, biosurfactants, bioremediation, bioeconomy…
- Research toward the next generation of eco-friendly, greener, and affordable biopharmaceuticals
- Bioactive materials for health and sustainability
- Biotechnologically relevant enzymes and directed evolution
-

Jasmina Nikodinovic-Runic
Full research professorEco-biotechnology and drug development
Department of Microbiology and Plant BiologyJasmina Nikodinovic-Runic, PhD, is a Principal Research Fellow at the Institute of Molecular Genetics and Genetic Engineering, University of Belgrade, where she leads the Group for Eco-Biotechnology and Drug Development. Her team is dedicated to developing sustainable biotechnological solutions to global challenges such as plastic pollution and the rise of antimicrobial resistance. She earned her PhD from the University of New South Wales (Sydney, Australia), focusing on the biosynthesis of amphotericin B, a natural antifungal product from Streptomycetes. Following postdoctoral research in the United States and Ireland, she continued her scientific and academic career in Serbia.
Her research centers on innovative approaches in biocatalysis, bioactive bacterial metabolites and the functionalization of bacterial biopolymers, such as bacterial nanocellulose and polyhydroxyalkanoates. She also works on transforming plastic waste into valuable biopigments and biopolymers.
Through numerous national and international projects, including H2020, Horizon Europe and EIC Pathfinder initiatives, Dr Nikodinovic-Runic contributes to the advancement of circular bioeconomy and the development of environmentally friendly technologies. Her scientific achievements include the development and application of efficient biocatalysts, the use of bacterial products in combating fungal and cancer-related diseases and the improvement of methodologies for biopolymer synthesis. She is one of the authors of four international patents in biotechnology and has mentored over twenty PhD candidates, both in Serbia and abroad, significantly contributing to the growth of the next generation of researchers. She is an active member of several European and global scientific societies and serves on the editorial boards of leading journals, underscoring her international recognition in applied microbiology and biocatalysis.
Beyond research, she is deeply engaged in science communication through academic and public channels. She strongly advocates for bridging academia and industry through innovation-driven projects, as well as for strengthening interdisciplinary collaborations between science and the arts.
-
FULL RESEARCH PROFESSOR
ASSOCIATE RESEARCH PROFESSOR
ASSISTANT RESEARCH PROFESSOR
RESEARCH ASSISTANT
JUNIOR RESEARCHER
RESEARCHERS
-
Key publications
- Nenadovic M, Ponjavic M, Pantelic B, Guzik M, Majka TM, Sourkouni G, Maršavelski A, Nikodinovic-Runic J. Efficient degradation of consumer-grade PLA by commercial Savinase: optimized conditions and molecular dynamics insights. ACS Sustain Chem Eng 2025;13(24):9269. doi: 10.1021/acssuschemeng.5c02063
- Filipovic V, Nikodinovic-Runic J, Savikin K, Zivkovic J, Mudric J, Krgovic N, Ponjavic M. Bacterial nanocellulose and its oxidized form as functional carriers for pomegranate peel extract: a sustainable approach to bioactive delivery. Future Foods. 2025;11:100560. doi: 10.1016/j.fufo.2025.100560
- Skaro Bogojevic S, Krstić Đ, Filipovic V, Pantelic L, Nikodinovic-Runic J, Trifković J, Vojnovic S, Simic J. Organic and natural deep eutectic solvents for the extraction of bacterial prodiginine biopigments. J Mol Liq. 2025;434:128063. doi: 10.1016/j.molliq.2024.128063
- Nenadovic M, Maršavelski A, Škaro Bogojević S, Maslak V, Nikodinović-Runić J, Milovanović J. New model compounds for the efficient colorimetric screening of medium chain length polyhydroxyalkanoate (mcl-PHA) depolymerases reveal mechanism of activity. Int J Biol Macromol. 2024;283(Pt 3):137672. doi: 10.1016/j.ijbiomac.2024.137672
- Malagurski I, Lazic J, Ilić-Tomic T, Salevic A, Guzik M, Krzan M, Nikodinovic-Runic J, Ponjavic M. Double layer bacterial nanocellulose–poly(hydroxyoctanoate) film activated by prodigiosin as sustainable, transparent, UV-blocking material. Int J Biol Macromol. 2024;279(Pt 1):135087. doi: 10.1016/j.ijbiomac.2024.135087